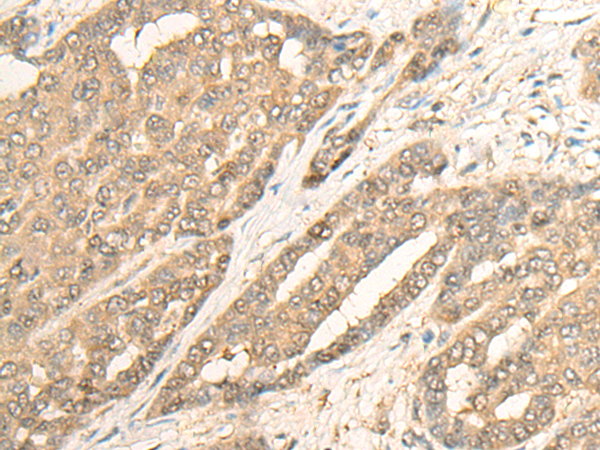

英文名稱: Anti-IMPA1 rabbit polyclonal antibody
標 記 物: Unconjugate
技術(shù)規(guī)格
|
Background: |
This gene encodes an enzyme that dephosphorylates myo-inositol monophosphate to generate free myo-inositol, a precursor of phosphatidylinositol, and is therefore an important modulator of intracellular signal transduction via the production of the second messengers myoinositol 1,4,5-trisphosphate and diacylglycerol. This enzyme can also use myo-inositol-1,3-diphosphate, myo-inositol-1,4-diphosphate, scyllo-inositol-phosphate, glucose-1-phosphate, glucose-6-phosphate, fructose-1-phosphate, beta-glycerophosphate, and 2'-AMP as substrates. This enzyme shows magnesium-dependent phosphatase activity and is inhibited by therapeutic concentrations of lithium. Inhibition of inositol monophosphate hydroylosis and subsequent depletion of inositol for phosphatidylinositol synthesis may explain the anti-manic and anti-depressive effects of lithium administered to treat bipolar disorder. Alternative splicing results in multiple transcript variants encoding distinct isoforms. A pseudogene of this gene is also present on chromosome 8q21.13. |
|
Applications: |
ELISA, WB, IHC |
|
Name of antibody: |
IMPA1 |
|
Immunogen: |
Fusion protein of human IMPA1 |
|
Full name: |
inositol monophosphatase 1 |
|
Synonyms: |
IMP; IMPA |
|
SwissProt: |
P29218 |
|
ELISA Recommended dilution: |
5000-10000 |
|
IHC positive control: |
Human liver cancer and Human esophagus cancer |
|
IHC Recommend dilution: |
25-100 |
|
WB Predicted band size: |
30 kDa |
|
WB Positive control: |
Human cerebrum tissue lysate |
|
WB Recommended dilution: |
500-2000 |

購物車
購物車 幫助
幫助
 021-54845833/15800441009
021-54845833/15800441009
